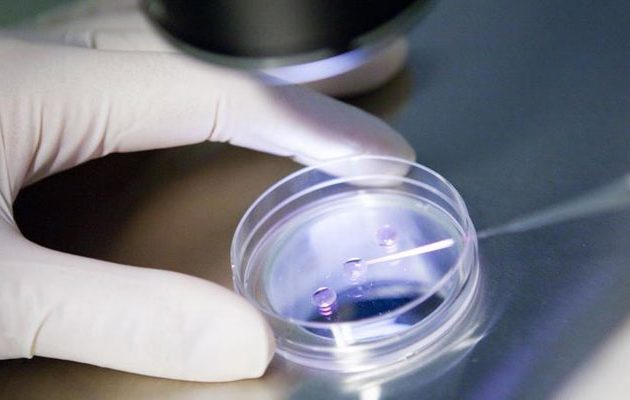
Κλινική στην Ολλανδία γονιμοποίησε 26 γυναίκες με λάθος σπέρμα

ΔΕΙΤΕ ΠΡΩΤΟΙ ΟΛΑ ΤΑ ΝΕΑ ΤΟΥ TRIBUNE ΣΤΟ GOOGLE NEWS
ΔΕΙΤΕ ΠΡΩΤΟΙ ΟΛΑ ΤΑ ΝΕΑ ΤΟΥ TRIBUNE ΣΤΟ GOOGLE NEWS 
Διαβάστε σχετικά για Ολλανδία, Σπερματοζωάριο,


















































 Ένας Έλληνας, ο Κώστας Μαστοράκης, στο τιμόνι της Nazionale Piloti: Ιστορική αλλαγή φρουράς στο Μονακό με άρωμα Μυκόνου
Ένας Έλληνας, ο Κώστας Μαστοράκης, στο τιμόνι της Nazionale Piloti: Ιστορική αλλαγή φρουράς στο Μονακό με άρωμα Μυκόνου  Απελάθηκε αλλοδαπή που έστελνε απειλητικά μηνύματα στη Χριστίνα Παππά - Μια ιστορία φιλανθρωπίας
Απελάθηκε αλλοδαπή που έστελνε απειλητικά μηνύματα στη Χριστίνα Παππά - Μια ιστορία φιλανθρωπίας  Το Ιράν επιτέθηκε σε Κουβέιτ και Μπαχρέιν - Οι ΗΠΑ βομβάρδισαν ιρανικά ραντάρ
Το Ιράν επιτέθηκε σε Κουβέιτ και Μπαχρέιν - Οι ΗΠΑ βομβάρδισαν ιρανικά ραντάρ  Άννα Παπαδοπούλου (ΕΛ.Α.Σ.): Ο Κυρανάκης ΔΕΝ αναβάθμισε το σιδηροδρομικό δίκτυο και ο Μητσοτάκης τον έχρισε γραμματέα της ΝΔ
Άννα Παπαδοπούλου (ΕΛ.Α.Σ.): Ο Κυρανάκης ΔΕΝ αναβάθμισε το σιδηροδρομικό δίκτυο και ο Μητσοτάκης τον έχρισε γραμματέα της ΝΔ  Αττική: Εξαρθρώθηκε κύκλωμα διαφθοράς σε Πολεοδομίες - Οι «ταρίφες», τα συνθηματικά και οι κώδικες επικοινωνίας
Αττική: Εξαρθρώθηκε κύκλωμα διαφθοράς σε Πολεοδομίες - Οι «ταρίφες», τα συνθηματικά και οι κώδικες επικοινωνίας
ΔΕΙΤΕ ΠΡΩΤΟΙ ΟΛΑ ΤΑ ΝΕΑ ΤΟΥ TRIBUNE ΣΤΟ GOOGLE NEWS
ΔΕΙΤΕ ΠΡΩΤΟΙ ΟΛΑ ΤΑ ΝΕΑ ΤΟΥ TRIBUNE ΣΤΟ GOOGLE NEWS 
Ενα επαναλαμβανόμενο διαδικαστικό σφάλμα σε κλινική θεραπείας υπογονιμότητας, οδήγησε πιθανόν στη γονιμοποίηση ωαρίων 26 γυναικών με λάθος σπέρμα.
Το «διαδικαστικό σφάλμα», συνέβαινε από τα μέσα Απριλίου του 2015 μέχρι τα μέσα του περασμένου Νοεμβρίου, σύμφωνα με την ανακοίνωση που εξέδωσε η ίδια η κλινική.
«Στη διάρκεια της γονιμοποίησης σπερματικά κύτταρα ενός ζεύγους που υποβάλλεται σε θεραπεία ίσως αναμείχθηκαν με τα ωάρια άλλων 26 ζευγαριών. Υπάρχει η πιθανότητα τα ωάρια να γονιμοποιήθηκαν με σπέρμα κάποιου άλλου απ’ τον πατέρα», αναφέρει.
Οι υπεύθυνοι της κλινικής UMC, που εδρεύει στην Ουτρέχτη, είπαν ότι η πιθανότητα να έχει συμβεί κάτι τέτοιο είναι μεν μικρή, αλλά «δεν μπορεί να αποκλειστεί».
Όμως, οι μισές απ’ τις γυναίκες που υποβλήθηκαν στη θεραπεία είναι τώρα έγκυες ή έχουν ήδη γεννήσει.
Το «διαδικαστικό σφάλμα» ανακαλύφθηκε όταν τέθηκε σε εφαρμογή μια νέα διαδικασία στο ιατρικό κέντρο.





























































